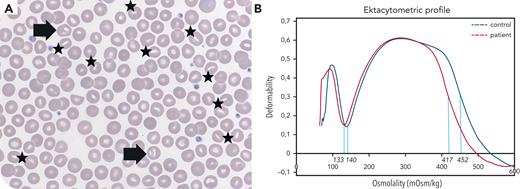
graphic

A 52-year-old man with incidentally discovered polycythemia was referred to hematology. He had no relevant medical history, and clinical examination was normal. Blood tests showed hemoglobin 19 g/dL, hematocrit 51%, normal mean corpuscular volume 86.8 fL, and an abnormally high mean corpuscular hemoglobin concentration of >36.5 g/dL. Erythropoietin was atypically normal at 9.3 mU/mL. There was no JAK2 mutation. Peripheral blood smear (panel A; 63× lens objective, May-Grünwald-Giemsa stain) showed some stomatocytes (stars) and rare knizocytes (arrows). Ferritin was high at 936 ng/mL, indicating iron overload necessitating further evaluation by magnetic resonance imaging, despite normal liver function test results. There was no stigmate of hemolysis, except for a high reticulocyte count of 174 000/μL (2.94%). A venous blood hemoglobin-oxygen affinity test result of 22.5 mm Hg suggested increased oxygen affinity. Ektacytometry indicated a left-shifted curve with a moderately dehydrated osmotic gradient profile (panel B; Hematology Laboratory, Bicêtre Hospital). Genetic analysis identified a heterozygous PIEZO1 mutation of c.6812A>G p(Glu2271Gly), predicted to be pathogenic by AlphaMissense. Further functional assays are required to identify the pathogenic role of this unreported variant.
PIEZO1 gain-of-function mutations cause increased calcium influx, potassium, and water leakage, resulting in dehydrated red blood cells. Heterogeneous phenotypes, including predominant erythrocytosis, pose diagnostic challenges. The blood smear played a crucial role in redirecting the diagnosis toward an unexpected PIEZO1 hereditary xerocytosis. This case underscores the importance of comprehensive diagnostic approaches, combining clinical, genetic, and morphological assessments for accurate identification of rare blood disorders.
For additional images, visit the ASH Image Bank, a reference and teaching tool that is continually updated with new atlas and case study images. For more information, visit https://imagebank.hematology.org.

This feature is available to Subscribers Only
Sign In or Create an Account Close Modal